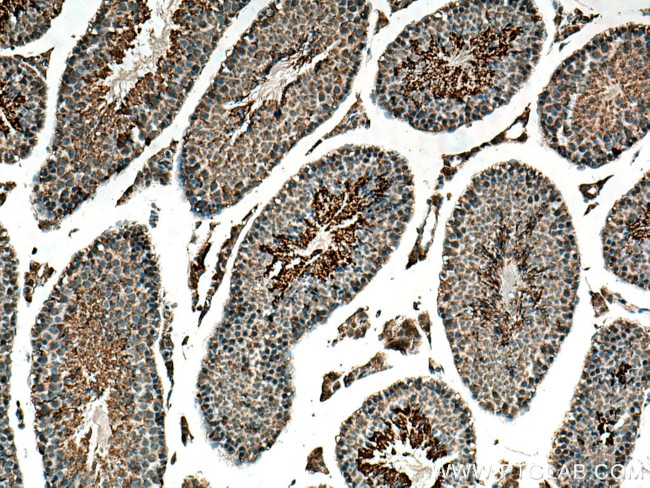
GPD2 Antibody in Immunohistochemistry (Paraffin) (IHC (P))

Search
Proteintech
GPD2 Polyclonal Antibody
{{$productOrderCtrl.translations['antibody.pdp.commerceCard.promotion.promotions']}}
{{$productOrderCtrl.translations['antibody.pdp.commerceCard.promotion.viewpromo']}}
{{$productOrderCtrl.translations['antibody.pdp.commerceCard.promotion.promocode']}}: {{promo.promoCode}} {{promo.promoTitle}} {{promo.promoDescription}}. {{$productOrderCtrl.translations['antibody.pdp.commerceCard.promotion.learnmore']}}
产品信息
17219-1-AP
种属反应
已发表种属
宿主/亚型
分类
类型
抗原
偶联物
形式
浓度
规格
纯化类型
保存液
内含物
保存条件
运输条件
产品详细信息
Immunogen sequence: KAVKGTLVG GGALATVLGL SQFAHYRRKQ MNLAYVKAAD CISEPVNREP PSREAQLLTL QNTSEFDILV IGGGATGSGC ALDAVTRGLK TALVERDDFS SGTSSRSTKL IHGGVRYLQK AIMKLDIEQY RMVKEALHER ANLLEIAPHL SAPLPIMLPV YKWWQLPYYW VGIKLYDLVA GSNCLKSSYV LSKSRALEHF PMLQKDKLVG AIVYYDGQHN DARMNLAIAL TAARYGAATA NYMEVVSLLK KTDPQTGKVH VSGARCKDVL TGQEFDVRAK CVINATGPFT DSVRKMDDKD AAAICQPSAG VHIVMPGYYS PESMGLLDPA TSDGRVIFFL PWQKMTIAGT TDTPTDVTHH PIPSEEDINF ILNEV (5-378 aa encoded by BC019874)
靶标信息
Mitochondrial glycerophosphate dehydrogenase (EC 1. 1. 99. 5), or GPD2, is located on the outer surface of the inner mitochondrial membrane and catalyzes the unidirectional conversion of glycerol-3-phosphate (G-3-P) to dihydroxyacetone phosphate (DHAP) with concomitant reduction of the enzyme-bound FAD. Together with a cytosolic NAD-linked GPD (GPD1; MIM 138420), GPD2 forms the glycerol phosphate shuttle, which uses the interconversion of G-3-P and DHAP to transfer reducing equivalents into mitochondria, resulting in the reoxidation of NADH formed during glycolysis.
仅用于科研。不用于诊断过程。未经明确授权不得转售。
生物信息学
蛋白别名: FAD-linked glycerol-3-phosphate dehydrogenase; glycerol phosphate dehydrogenase 1, mitochondrial; Glycerol-3-phosophate dehydrogenase 2 (mitochondrial); glycerol-3-phosphate dehydrogenase 2 (mitochondrial); glycerol-3-phosphate dehydrogenase 2 (mitochondrial) isoform GPD2_1; glycerol-3-phosphate dehydrogenase 2 (mitochondrial) isoform GPD2_2; glycerol-3-phosphate dehydrogenase 2, mitochondrial; Glycerol-3-phosphate dehydrogenase, mitochondrial; GPD-M; GPD3; GPDH-M; mGDH; mitochondrial glycerol-3-phosphate dehydrogenase; mitochondrial glycerophosphate dehydrogenase; mitochondrial glycerophosphate dehydrogenase gene; mitohondrial glycerophosphate dehydrogenase; mtGPD; mtGPDH gene, promoter region and alternative transcripts; Protein TISP38; testicular tissue protein Li 76; unnamed protein product
基因别名: AA408484; AI448216; AU021455; AW494132; GDH2; Gdm1; Gpd-m; GPD2; GPDH; Gpdh-m; GPDM; mGDH; mGPDH; mtGPDH; TISP38
UniProt ID: (Human) P43304, (Mouse) Q64521, (Rat) P35571
Entrez Gene ID: (Human) 2820, (Mouse) 14571, (Rat) 25062